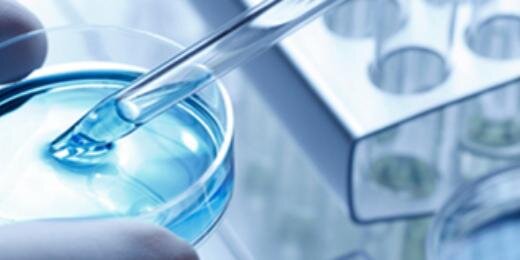
CID4 banner

CID4
450 posts

CID4
@CID4Colorado
The Colorado Institute for Drug, Device and Diagnostic Development (CID4) - transforming life science innovation into commercial success. Call (720) 859-4043
Aurora, Colorado USA Katılım Ocak 2010
131 Takip Edilen976 Takipçiler

Welcome, Ginny Orndorff: "CID4 names director to succeed Kevin Smith"... fb.me/6jO7nsjda
English

Welcome, Ginny Orndorff: "CID4 names director to succeed Kevin Smith"... fb.me/20RIIozSp
English

Welcome, Ginny Orndorff: "CID4 names director to succeed Kevin Smith" innovationews.com/science/biosci…
English

Aurora Sentinel: CID4 'bioscience boss stepping down' ow.ly/GzaVS @quincysnowdon via @CID4Colorado fb.me/7ceSsI7iY
English

Aurora Sentinel: CID4 'bioscience boss stepping down' ow.ly/GzbtG @quincysnowdon
English
CID4 retweetledi

Aurora: @CID4Colorado ED 'applicants sought by Dec. 20' ow.ly/FNKQ5 @innov_news via @COBioScience fb.me/6TY2rWQ1U
English
CID4 retweetledi

@cobioscience @innov_news @CID4Colorado @kevinmstar Best wishes, Kevin! Thanks for supporting our #Colorado #startup community!
English

TechFlash: 'Colorado bioscience organization searches for new leadership' ow.ly/EPfEi @GregAveryDenBiz
English

InnovatioNews: 'Kevin Smith to retire from leadership of CID4 on Dec. 31' ow.ly/EOPrZ @innov_news via... fb.me/2PoNayWX4
English

InnovatioNews: 'Kevin Smith to retire from leadership of CID4 on Dec. 31' ow.ly/EOPM3 @innov_news
English

DeviceSpace: 'Kevin M. Smith To Retire As CEO Of CID4; Search Committee To Hire Smith’s Successor'... fb.me/2NICTQV8s
English

DeviceSpace: 'Kevin M. Smith To Retire As CEO Of CID4; Search Committee To Hire Smith’s Successor' ow.ly/EOMXZ
English

#Denver Life Sci Exec Kevin M Smith to Retire as #CEO; Search for Successor Launched ow.ly/ENGmp via... fb.me/7ti94ozX1
English
